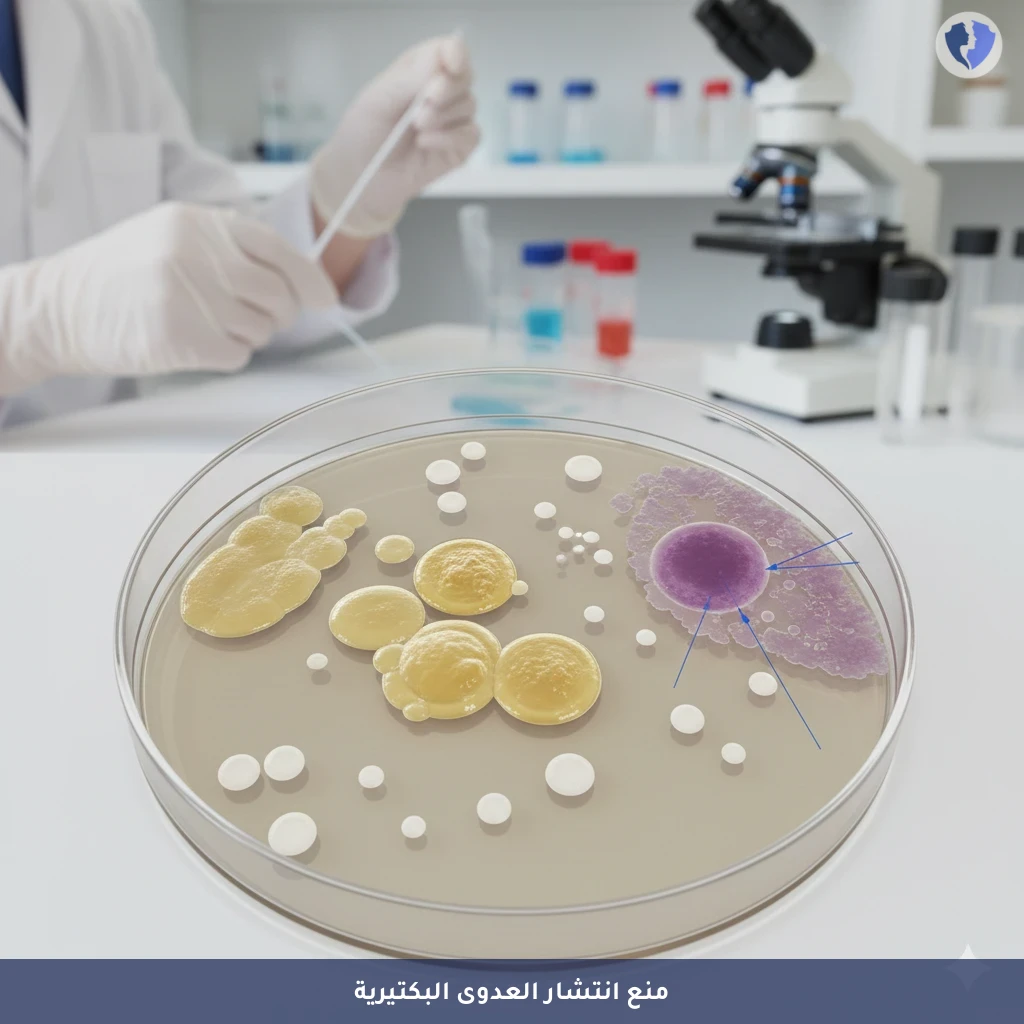
فحص بكتيريا المستشفيات المقاومة - فحص بكتيريا المكورات العنقودية المقاومة للميثيسيلين (MRSA)

تفاصيل الخدمة
فحص بكتيريا المستشفيات المقاومة - فحص بكتيريا المكورات العنقودية المقاومة للميثيسيلين (MRSA)
فحص ميكروبيولوجي للكشف عن وجود بكتيريا المكورات العنقودية الذهبية المقاومة للميثيسيلين (Methicillin-Resistant Staphylococcus aureus - MRSA) دون أن تسبب عدوى نشطة (أي حالة "حامل" - colonization). يتم إجراؤه عادةً بمسح مناطق شائعة للحمل مثل الأنف (المنخرين)، والإبطين، ومنطقة العانة، باستخدام مسحة معقمة. يهدف الفحص إلى منع انتشار هذه البكتيريا المقاومة للمضادات الحيوية في المستشفيات ومرافق الرعاية الصحية، خاصة قبل العمليات الجراحية أو عند دخول وحدات العناية المركزة.